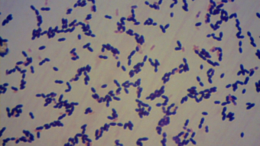

Novel Technique Helps Discover Whether Bacteria That Cause Meningitis are Resistant to Antibiotics
A study published in the journal PLOS ONE could one day help healthcare professionals determine whether bacteria of the species Streptococcus pneumoniae, which cause meningitis are resistant to antibiotics. This…